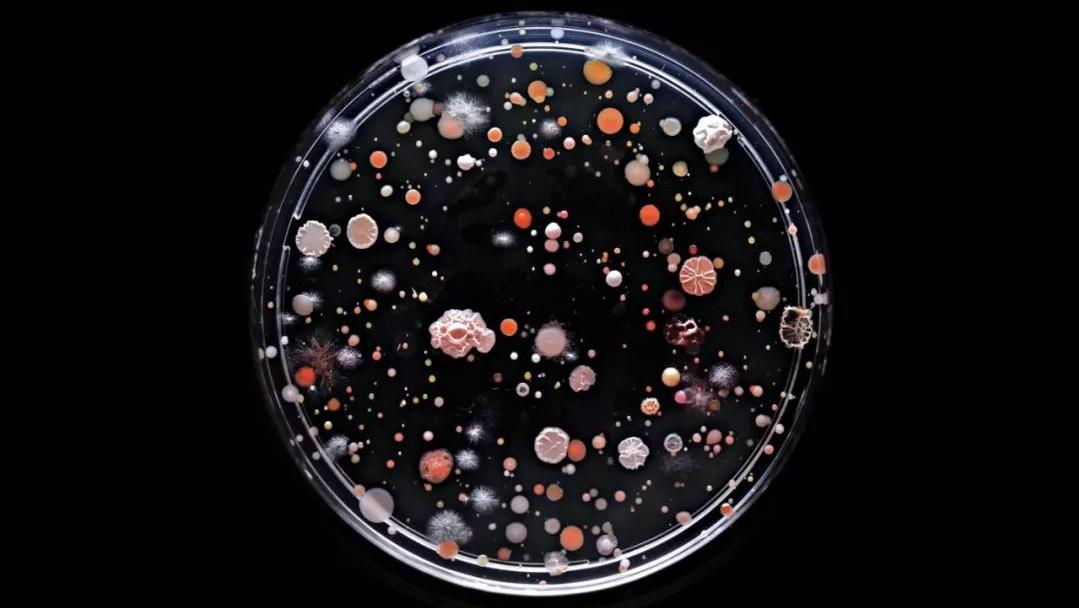
女性清洗*处私**时，要掌握这三个方法，避免感染妇科病，你学会了吗

张女士是一个很爱卫生的人,几乎每天都会洗澡,*处私**也不是一带而过,而是认真清洗。对于她来说,哪怕是手碰到陌生的地方,都要及时拿出湿巾或者手帕擦拭干净。
这天,正在上班的张女士顿感*处私**一阵瘙痒,碍于是在公共场合,张女士并没有及时查看。回到家后,张女士连忙检查是怎么回事,发现自己的外阴部分出现了明显的红肿。
作为十分讲究个人卫生的张女士,第一反应是过敏了,本欲抹一点皮肤药。不过思考片刻,张女士还是抱着一查到底的态度决定去医院。次日,张女士请假来到医院。医生简单的看了看外阴情况,说“可能是阴道炎,要采样检查一下。”

张女士不解,自己平时这么讲究个人卫生,还能患炎症了?而取样时,医生从阴道中弄出的白色粘稠液体更是恶心到了张女士。这种物质稀薄、伴有刺鼻的臭味,不同于普通的白带。
结果出来后,张女士患的是滴虫性阴道炎,吃一点抗生素就没事了。医生还解释道,张女士正是因为清洗次数频繁,方法也不太对,导致阴道内菌群被破坏,从而给了有害细菌滋生的机会。
清洗下面还要讲究方法?张女士登时愣住了,没想到爱干净还有错?大夫笑着解释说,讲卫生当然是我们提倡的,但是过分洁癖就可能起到适得其反的效果了。有很多妇科炎症或者妇科疾病就是因为患者太爱干净了,或者说爱干净的方式不对。

这些妇科炎症,是因为你“太爱干净”!
女性外阴,顾名思义就是外生殖器,是阴道入口处一些结构的总称。
这些结构包括阴阜、阴唇、前庭、阴蒂等。女性外生殖器官可以使女性准确感知刺激,并且可以保护内生殖系统。
而女性生殖器的保护作用是机体天然形成的,分为物理保护和化学保护。女性外生殖器官的物理保护主要是有这几点。
阴道外侧端要比内侧端狭窄,所以从解剖角度看,阴道口多数时间是关闭的,阻止了大部分病原微生物进入到阴道内;此外,大阴唇、小阴唇在未经过刺激或病理影响的情况下也是闭合的,可以阻断病原微生物的侵袭,对阴道起保护作用;而且阴道上细胞角化,这亦可以使阴道上的黏膜抵抗阴道内病原体的入侵。
另外就是化学保护,阴道在正常情况下是呈酸性环境的,抑制了许多只能在碱性空间下才能生存和繁殖的病原体。而子宫颈管同样可以分泌黏液,这些黏液呈碱性,抑制了很多只能在酸性环境下才能繁衍的病原微生物。两者共同作用保持阴道的清洁。
除此之外,健康的女性阴道内还存在着类似于革兰氏阳性需氧菌、革兰氏阴性需氧菌、假丝酵母菌等许多种类的微生物。这些微生物互相依赖并且互相制衡,帮助阴道达到动态的生态平衡,防止女性生殖道感染。

正是因为“层层加码”的保护,才保证了女性最私密部位的安全和卫生。不过阴道外口是经血的流出口和夫妻生活的入口,又距离尿道口和肛门距离近,再加上阴部汗腺较多,平时多处于封闭的场所。这就导致阴道口可能会滋生大量的细菌和病原微生物,所以日常生活中,定时清洗外阴是很有必要的。
不过如果不掌握正确的方法,不但没有达到杀菌清洁的目的,反而会适得其反,增加妇科疾病的患病率。
本身阴部的皮肤稍显脆弱,一些女性患者冲洗太频繁、水温太高、毛巾质地过于坚硬、洗的时候手劲儿过大,都可能造成皮肤的破溃和损伤。又因为阴部毛发旺盛,皮肤损伤不易发现,就会导致伤口感染,引起一系列外阴疾病。

还有一些人喜欢冲洗阴道,这本身就是不对的。
临床上建议正常女性一般情况下不冲洗阴道。因为阴道内的正常菌群足够抵御大部分病原微生物了。过多地冲洗阴道会破坏阴道内正常的酸碱平衡,这会导致原来被抑制的病源微生物生长繁殖,大大提升了阴道内侧甚至输卵管、宫颈、宫腔的器官炎症或者病变。
所以爱干净之心,人皆有之,但如何正确地追求卫生,则需要讲求方法。

掌握这三个方法,才能真正告别细菌
我认为,想要真正的保护*处私**,无外乎以下三种方法。
1、水的选择别马虎
正如上文所说,定时清洗外阴是很有必要的,那么就要注意水的选择。
首先是水温不能过高。阴部毛细血管旺盛,水温过高可能会导致毛细血管整体扩张,时间久了会引起毛细血管曲张、内分泌失调,提高疾病的发病率。
因为阴部皮肤整体较为薄弱,抵抗力更差,毛囊更脆。水温太高很可能烫伤局部皮肤组织和毛囊组织,造成皮肤炎症或者毛囊炎症,降低*体下**的抵抗力,从而导致外阴炎症的出现。
其次,就是尽量选择清水,不要轻易尝试各种各样的冲洗液和清洗剂。这是因为这些冲洗液的化学成分可能随着水流到达阴道内部,破坏阴道内的正常菌群,降低阴道内部抵御病原微生物的能力。
还有就是这些化学成分可能破坏阴道内的酸碱平衡,同样不利于预防疾病。再者本身化学物品多少会带有一些刺激性,阴道内部、输卵管、宫颈处的纤毛上皮结构本身偏脆弱,很容易被不良刺激。
另外就是清洗阴部最好有一个专用盆,以免换盆导致不明细菌附着到外阴或者进入到内阴。

2、清洗顺序不得随意
我们清洗外阴,本质目的是为了消灭病原微生物,但是如果不讲究顺序方法,很可能病原微生物就会逆流进生殖部位内侧。
临床推荐的清洗顺序是,先由外向内,再由内向外。意思就是先从大阴唇内侧开始,向内侧清洗小阴唇,阴蒂周围和阴道前庭,然后再清洗大阴唇外侧、阴阜、大腿根等,最后可以洗一下肛门。
这个清洗顺序可以最大化清洁作用,达到事半功倍的效果。

3、便后处理以及贴身衣物的盥洗
由于女性特殊的解剖结构,所以便后处理也是非常重要的。小便后可以多拿几张干净的纸巾在尿道口轻轻贴几下,吸取粘在肌肤上的尿液。大便后尽量从前往后擦,以免残留物碰到生殖器。
此外就是避免*裤内**或者裤子穿的太紧,这样同样会导致毛细血管扩张,局部皮肤受压,时间久了可能会出现瘙痒、炎症等。而且贴身衣物一定要经常换洗,避免阴道分泌物、汗渍等附着于皮肤上。
写在最后
外阴清洗是必要的,只要注意细节,就能保持外阴部位的卫生和干燥。不可因小失大,因为错误清洗亦可造成不适症状出现。
参考文献
1.李顺今,李国宏,李成哲,金英华.生活习惯与霉菌性阴道炎关系的探讨[J].中国妇幼保健